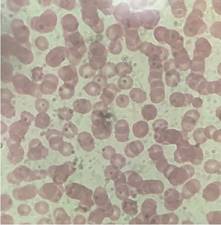
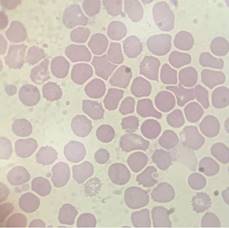

1. Introducción
El hombre no fue consciente de que era sangre lo que circulaba por su cuerpo hasta que William Harvey la describió en 1616. En 1674, Anton van Leeuwenhoek describió los glóbulos rojos gracias a sus inventos, y desde entonces se iniciaron más estudios en esta área (Murillo, 2019). Posteriormente, en 1747, Magendie descubrió que existía hierro en la sangre al calentar la sangre hasta volverla cenizas y comprobar que éstas eran atraídas por un imán. En 1902, Bunge descubrió que consumir alimentos con baja cantidad de hierro puede provocar anemia. En 1931, el Dr. Kaznelson descubrió que cuando uno padece anemia se puede presentar algunos cambios físicos como deformación de las uñas y palidez (Pérez, 2016).
Es de esta forma que se fue estudiando la anemia hasta definirla como la enfermedad que se produce cuando hay una cantidad inferior a la normal de glóbulos rojos. Es una enfermedad muy conocida y se ha ido clasificando según su causa y los cambios que produce. La anemia puede producirse por deficiencia de hierro o de vitamina B12, o la conocida como hemolítica. En general se caracteriza por producir debilidad, sueño y cansancio por la pérdida del oxígeno que hay en los glóbulos rojos (NIH, 2023).
La anemia es una enfermedad que afecta a toda la población en general, con mayor frecuencia en niños y mujeres, y en su etapa inicial puede no significar un grave peligro. Para realizar el diagnóstico de la anemia se deben realizar estudios previos que nos compruebe que los niveles de glóbulos rojos son diferentes a los normales. Para tener este estudio se realiza un hemograma completo. Éste es un conjunto de análisis que incluye estudios de los niveles de glóbulos rojos, de hemoglobina, de hematocrito y un análisis de los niveles del volumen corpuscular medio (MCV). Cada indicador mencionado anteriormente tiene un rango adecuado que depende de la altitud donde vive la personas y su género. Cuando alguno de los indicadores no está en los rangos normales, se diagnostica la anemia o alguna otra enfermedad relacionada a la sangre.
2. Misiones espaciales y anemia hemolítica
La anemia hemolítica es caracterizada por una destrucción de glóbulos rojos muy rápida, de manera que no se puede reemplazar la pérdida, lo que ocasiona que el organismo no cuente con un nivel de glóbulos rojos adecuado. Usualmente las causas de la anemia hemolítica son infecciones, transfusiones mal realizadas, talasemia o afecciones sanguíneas heredadas (NIH, 2023). Por ello, generalmente afecta a personas enfermas o con algún desorden en sus hábitos.
La anemia hemolítica es el caso más relacionado con la anemia en el espacio. Aunque usualmente la anemia afecta a personas con alguna enfermedad o algún hábito no saludable, también, por muy contradictorio que parezca, ha sido diagnosticada en astronautas. Estudios muestran que se reduce al menos un 10-15% de masa de glóbulos rojos solo en las primeras horas de vuelo en el espacio (Alfrey et al., 1996). Esto no es coherente si se considera la preparación física a la que los astronautas son sometidos, el riguroso control que tienen con sus hábitos y los análisis que tienen que realizarse para poder ir al espacio.
Los viajes al espacio han significado un gran paso en la tecnología del hombre. El hecho de que seamos capaces de conocer nuevos planetas y algún día tal vez habitarlos, motiva a muchos científicos a realizar investigaciones en el área. Las investigaciones no son solo para crear nueva tecnología, sino también para entender las características que debe tener un astronauta para poder sobrevivir en el espacio. De esta forma se busca cada día mejorar las herramientas de los astronautas y su preparación física y mental.
Debido a estas nuevas condiciones en el ambiente de los astronautas durante las misiones espaciales, el cuerpo sufre una serie de cambios, los cuales llegan a afectar el cuerpo de los astronautas. Por ejemplo: en la tierra, la gravedad hace que nuestro cuerpo esté apilado sobre sí mismo, manteniendo todo en su lugar; pero en el espacio, con la pérdida de gravedad, las vértebras se separan un poco y los astronautas pueden llegar a crecer unos tres centímetros. Por otro lado, en el sistema circulatorio se ha observado que el bombeo de sangre cambia. En la tierra la gravedad hace que la sangre se distribuya hacia la parte baja del cuerpo, pero en el espacio la microgravedad evita que esto pase, por lo que la sangre se queda estancada en la cabeza y puede llegar a ser doloroso para el astronauta, ya que les provoca dolores de cabeza y calambres en las piernas. Es por esto que se les recomienda que se pongan de cabeza para que así la sangre llegue a todas partes del cuerpo (USRA, 2023).
Estos cambios se deben a dos condiciones extremas que ocurren en el espacio: la microgravedad y la hipergravedad. Usualmente, los estudios espaciales se realizan en condiciones de microgravedad, que es la condición que el astronauta siente cuando uno ya está en el espacio, y que está definida como el estado en el que uno no siente gravedad (Duque, 2008)Ciencia en microgravedad, 2006). Otro fenómeno que sufren los astronautas y que no ha sido tan investigado es el de la hipergravedad, ya que a pesar de todas las pruebas a las que los astronautas son sometidos previas a las misiones espaciales, no se puede controlar el efecto que tiene la hipergravedad en su cuerpo.
La hipergravedad es un fenómeno en el que la gravedad es mayor a la que hay en la tierra, lo que ocasiona muchas alteraciones en el organismo por la fuerza que ejerce. Este fenómeno afecta a los astronautas en el momento en que los cohetes son lanzados al espacio, por la velocidad que se ejerce en ese instante, ya que se necesita la suficiente aceleración para que la nave traspase todas las capas de la tierra. Esta fuerza es tanta que si no se toman las precauciones necesarias llega a ser muy dañina.
Con la fuerza de la hipergravedad el organismo puede presentar distintos cambios, uno de los cuales es que el corazón cambia su forma de operar, bombeando más rápido para que la sangre llegue a todas las partes del cuerpo. Esto también ocasiona que los astronautas tengan mareos y náuseas. Es por eso que en el momento del despegue los astronautas deben encontrarse en la posición indicada para evitar algún daño.
De igual forma, los científicos siempre buscan nuevas formas para mejorar las condiciones de viaje de los astronautas, por lo que existen diferentes pruebas que están siendo actualmente realizadas en las instalaciones de la NASA, en las cuales someten a personas a gravedades de 2G. Para estas pruebas se utiliza una herramienta de gravedad artificial que es generada por una centrífuga de largo diámetro que es encargada de simular este cambio. Con este experimento se está buscando analizar los cambios en el reacondicionamiento vascular de las personas, por lo que se toman toda clase de datos sobre los signos vitales de los sujetos de estudio, esperando entender los cambios en el espacio (NASA, 2023).
Cuando un astronauta se somete a una misión espacial, ésta puede durar días, semanas o meses. El tiempo que tarda el cohete en llegar a la estación internacional en el espacio es de una duración de aproximadamente seis horas, dependiendo de la nave que se utilice. El tiempo que tarda el cohete a llegar a la Karman line, que es el nombre que se le da a la línea de la órbita de la tierra, es aproximadamente entre 3 a 5 minutos; éste es el tiempo que el astronauta estará expuesto a la hipergravedad, ya que después de esto se llega a la microgravedad, cuando la nave llega a la estación espacial internacional (Te Awamutu Space Center, 2023). Se dice que una persona normal solo puede resistir 8 G durante 1.40 min, y el tiempo disminuye a medida que aumentan las gravedades. Esto significa que se debe tomar en cuenta el hecho de que el cambio a estas gravedades ocurre en minutos, es decir, muy rápidamente. Es por esto que la fuerza de la hipergravedad tiene un gran impacto en el cuerpo, pudiendo llegar a ser una causante de la anemia espacial.
Aún no se ha encontrado la causa de la anemia espacial, ya que la poca disponibilidad de equipo que se tiene en el espacio impide que se determine de forma clara. Peor si los estudios que se han realizado sobre las consecuencias que se dan en los astronautas que vuelven del espacio revelan que la anemia puede durar hasta un año después del arribo del astronauta a la tierra. Asimismo, las complicaciones que se dan en la Tierra pueden ir en aumento si es que no se trata la enfermedad inmediatamente. Algo que se debe considerar también es que en el espacio el nivel de eritrocitos baja, provocando la anemia, pero solo hasta un cierto nivel en el que se llega a estabilizar durante todo el resto del viaje espacial. Recién una vez de vuelta en la Tierra es cuando se ven las dificultades. Esto quiere decir que en el espacio el astronauta no tiene dificultades producidas por la anemia; éstas solo se presentan a su vuelta (Trudel et al., 2022).
3. Osmosis
La osmosis es un proceso natural de difusión pasiva en el que, para lograr equilibrio, se produce el paso de las moléculas del solvente de una solución con menor concentración hacia otra que tiene mayor concentración. Esto se da entre dos soluciones separadas por una membrana semipermeable. Todo este proceso ocurre sin necesidad de energía, ya que se da gracias a la fuerza impulsora que se da entre la variante de concentración entre ambas soluciones. Esta propiedad es una característica física que se aprovecha en muchos organismos y es fundamental para la nutrición de todas las células (Universidad de Murcia, 2023).
La ósmosis es necesaria para que la célula pueda mantener el equilibrio dentro de su sistema, ya que permite que la célula, a través de su membrana, esté en constante contacto con su exterior. Esto significa que se encuentra en constante intercambio de componentes con su entorno, los cuales pueden ser nutrientes, iones, enzimas y proteínas, entre otros. Este intercambio mantiene en constante actividad a la célula.
La ósmosis puede ocurrir en dos diferentes medios. El primero se da cuando la concentración de una solución es menor con respecto a la segunda (medio hipotónico); el segundo, cuando la concentración es mayor en la segunda solución (medio hipertónico). Finalmente, cuando ambas concentraciones son iguales, y por lo tanto se encuentran en equilibrio, no se produce la ósmosis (medio isotónico) (Valdivielso, 2020).
En los eritrocitos este proceso es muy notorio, debido a que realiza cambios visibles en la célula. Para el eritrocito una solución isotónica sería a 0.9% de NaCl, porque ésa es la concentración que tiene la sangre; con esa concentración, no se presentan cambios en la membrana, denotando la salud del sujeto. Las soluciones con concentraciones menores a 0.9% de NaCl son hipotónicas, y en este entorno entra agua a través de la membrana semipermeable, haciendo que la célula se hinche, con el peligro de que se provoque la ruptura de la membrana. La comparación entre un glóbulo rojo normal y uno expuesto a una solución hipotónica puede observarse en las figuras 1 y 2.
En las imágenes se puede observar una muestra de sangre de una misma persona, expuesta a diferentes concentraciones. En la primera imagen se observa un eritrocito en el que se puede distinguir la membrana celular y el núcleo, lo cual nos confirma que la célula fue expuesta a un medio isotónico porque no hay cambios notorios en su estructura. En la segunda imagen es más notorio que no se distingue ningún núcleo ni ninguna otra estructura en la célula, debido a que la hemólisis, causada por un medio hipertónico, provocó que la célula se hinche.
Esta distinción es cualitativa, y aunque se observa que ciertas características han cambiado, no se puede cuantificar la diferencia entre los mismos. Es por esto que para poder realizar un análisis cuantitativo de las diferencias que tiene la sangre cuando está expuesta a diferentes concentraciones se realiza el test de fragilidad osmótica.
4. Test de fragilidad osmótica
El test de fragilidad osmótica es realizado en base al principio de la ósmosis. Es una prueba que se realiza para poder diagnosticar enfermedades como esfe- rocitosis hereditaria y talasemia. Ambas ocasionan que los glóbulos rojos sean más frágiles de lo normal, haciendo el eritrocito más susceptible a la lisis celular. Los resultados de la prueba deben ser negativos, para así estar seguros de que la persona no presenta ninguna de las dos condiciones, ya que un resultado positivo significa que se produce una muerte de eritrocitos; por lo tanto, nos indica un bajo de nivel de glóbulos rojos (Medline Plus, 2023).
Esta prueba consiste en extraer una muestra de sangre del paciente, analizarla y exponerla a soluciones hipotónicas con diferentes concentraciones, esperando que estas células experimenten cambios en su forma. Las células en este medio pueden llegar a hincharse y explotar debido a la cantidad de agua que entra; a este fenómeno se lo denomina hemólisis.
Para realizar la prueba de forma manual, se toma en cuenta la liberación de hemoglobina que se da en el momento de la lisis celular y se lee la absorbancia en un espectrofotómetro. Se espera que el dato de la absorbancia cambie con cada solución. Una vez obtenidos los datos de todas las soluciones, se realiza la gráfica de la curva.
Es posible evaluar la fragilidad osmótica por otros métodos, como la citometría de flujo, que de manera cualitativa (tamaño y complejidad) define la fragilidad osmótica de la célula en gráficos de FSC (Forward Scatter) vs SSC (Side Scater). Esta prueba también es de gran utilidad en el estudio de anemia hemolítica que se relaciona con la esferocitosis o talasemia. Pero estos test ya estandarizados son solo realizados en laboratorios especializados en el área (Cibic, 2018).
5. Estudios de fragilidad osmótica en Bolivia
En nuestro país existen pocos estudios sobre fragilidad osmótica en eritrocitos (Aliaga, 2021). No obstante, las características que presenta nuestro país hacen que las investigaciones en el mismo sean más relevantes, ya que la altura de la ciudad de La Paz (3600 msnm) representa una condición extrema. De hecho, es bien conocido que los habitantes en la altura tienen una mayor cantidad de glóbulos rojos, que y al ir a ciudades a nivel del mar sufren hemolisis debido a la adaptación a los nuevos niveles de oxígeno. E incluso existen estudios que prueban que un 10% de los habitantes de la ciudad de La Paz sufren de poliglobulia, o mal de altura, y que las personas de sexo masculino a partir de los 40 años tienden más a esta condición (Finlay, 2023). En este sentido, nuestro grupo de estudio ha optimizado la prueba de fragilidad osmótica para condiciones de altura.
6. Curva de fragilidad osmótica
Se realiza la toma de muestra de 4 ml de sangre venosa y se vierte en tubos con anticoagulante EDTA, a temperatura ambiente. La muestra obtenida se centrifuga por 10 minutos a 2.000 revoluciones por minuto (rpm). Una vez concluido este tiempo, se observa cómo la sangre se separa en plasma y paquete globular. Se extrae el plasma de la muestra y se agrega la misma cantidad extraída en solución Buffer pH 7.4 a concentración de 0.9% de NaCl.
Posteriormente, se preparan 12 soluciones de NaCl con las siguientes concentraciones: 0.0%, 0.1%, 0.2%, 0.25%, 0.3%, 0.32%, 0.36%, 0.4%, 0.45%, 0.55%, 0.7% y 0.9%. Para realizar la prueba se toman 4 ml de cada solución de NaCl y se agregan 40 μL de sangre, los mismos que se llevan nuevamente a la centrifugadora por 10 minutos a 2.000 rpm.
Una vez concluido el tiempo en la centrifugadora, se realiza la lectura de las absorbancias en el espectrofotómetro. Se debe preparar además un blanco positivo y un blanco negativo. El blanco positivo será la absorbancia de la solución Buffer 7.4 al 0.9% sin sangre, y el blanco negativo en la solución de pH 7.4 al 0.0% con sangre. Con estos datos se obtiene el porcentaje de hemólisis y se grafica una curva de concentraciones de NaCl vs % de hemólisis.
Para obtener el porcentaje de hemólisis se utiliza la siguiente fórmula
Donde:
Abs x = Absorbancia de la muestra
Abs 0.9 =Absorbancia del blanco positivo
Abs 0.0 =Absorbancia del blanco negativo
Con la anterior fórmula se obtiene la curva de fragilidad osmótica (Figura 3). En la figura se observa que existe una caída en la lectura de absorbancia de la muestra sometida a diferentes concentraciones de NaCl, y que ésta es de alrededor de 0.32%, lo que indica que desde ese punto empieza a ocurrir la hemólisis.
Todas las pruebas fueron realizadas en las instalaciones de la Universidad Católica Boliviana con una centrifugadora de mesa plc-03 rotor A-1215 de capacidad de 12 tubos de 15 ml y rotor de 6 cm de diámetro.
7. Hipergravedad y fragilidad osmótica
La hipergravedad supone un cambio trascendental en las condiciones del cuerpo de los astronautas. En un viaje espacial el astronauta puede llegar a alcanzar hasta 6-7 gravedades, dependiendo de la masa, antes de llegar a la microgravedad, lo que significa que el tiempo que sufren hipergravedad no es muy extenso (Despegalo, 2023).
La exposición a las fuerzas G afecta significativamente los valores de los glóbulos rojos. Sin embargo, se ha mostrado que la hipergravedad afecta en la deformación de los eritrocitos, lo cual está asociado con la viscosidad celular (Grau et al, 2017) y las propiedades mecánicas de la membrana (Mohandas y Chasis, 1993). Por otro lado, la hipergravedad conduce a la apoptosis de los reticulocitos (glóbulos rojos inmaduros) (Pecaut et al., 2004). Una razón para esto es que los reticulocitos no tienen proteínas de anclaje entre la membrana y el citoesqueleto (Stevens-Hernandez y Bruce, 2022). El aumento de la muerte de reticulocitos contribuye a la anemia.
Las fuerzas de gravedad no se pueden simular en las centrifugadoras comunes que se usan en laboratorio, ya que no tienen el radio lo suficientemente grande para llegar a gravedades mayores a 1. Por lo tanto, se requiere una centrifugadora de largo diámetro (CLD) que, al tener una longitud de 8 m, dependiendo de la posición donde se coloquen los tubos, puede alcanzar hasta 20 G.
Uno de los equipos que está capacitado para realizar esto es el que se encuentra en el Centro Europeo de Investigación y Tecnología Espacial (ESTEC, por sus siglas en inglés), perteneciente a la Agencia Espacial Europea (ESA, por sus siglas en inglés), ubicada en Noordwijk, Países Bajos. Se lo denomina Large Diameter Centrifuge (LDC). Esta centrifugadora es la más moderna de las dos existentes en el mundo, ya que en la NASA existe una centrifugadora con características parecidas, solo que es más antigua, porque fue fabricada en los años 60’s y tiene menos capacidad (ESA, 2023).
8. Mujeres haciendo ciencia espacial
Cuando se habla del espacio, la primera idea que nos viene a la cabeza es un astronauta, y si bien ya hay mujeres astronautas, son pocas las que han logrado este objetivo (73 mujeres vs. 525 hombres) (Duggirala et al., 2022). Igualmente, se conoce más el nombre de Yuri Gagarin, como el primer hombre que fue al espacio, que el de Valentina Tereshkova, que fue la primera mujer que lo hizo (Duggirala et al., 2022).Considerando que la ciencia espacial requiere no solo astronautas, sino ingenieros, matemáticos e informáticos, entre otros, es alarmante que solo el 20% de todos los puestos en la industria espacial internacional esté ocupado por mujeres (ONU, 2021)
Una iniciativa interesante para mejorar esta disparidad es la de Space 4 Women, de la Oficina de las Naciones Unidas para Asuntos el Espacio Ultraterrestre (UNOOSA), que busca dotar de oportunidades, desarrollar e inspirar a mujeres y niñas para ser futuras líderes en el campo espacial (Di Pippo et al., 2020).
En el caso de nuestro equipo, para tener acceso a la LDC se postuló a la convocatoria HyperGES, que está enmarcada en el programa “Espacio para todos” de la UNOOSA. Este programa favorece la participación de investigadores de países en vías en desarrollo y anima a postulantes femeninas para contribuir a la disminución en la brecha de género que se encuentra en investigaciones del área de ciencia, tecnología, ingeniería y matemáticas (CTIM).
El equipo boliviano que ganó la segunda convocatoria HyperGES es el primer equipo femenino y el más joven a la fecha (UNOOSA, 2023). El equipo está formado por estudiantes de la carrera de Ingeniería Bioquímica y Bioprocesos, y partió de un trabajo en la cátedra de Biología celular y molecular (Figura 4). Además del trabajo científico, las investigadoras deben cumplir con un indicador de difusión para asegurar que se disemine la idea de que la investigación espacial puede realizarse por mujeres jóvenes en nuestro país.
El trabajo con jóvenes científicas, si bien es desafiante por las limitaciones de tiempo y equipo, es también satisfactorio, porque es en las nuevas generaciones en las que se pretende despertar el espíritu investigativo.
En Bolivia, en general, no existe mucha ciencia, y el apoyo hacia la investigación es casi nulo. Algunas de las carencias incluyen la ausencia de un organismo como el Consejo de Ciencias y Tecnología (Martínez y Chávez, 2020), o la ausencia de semilleros científicos. Y si bien éstas son de alguna manera cubiertas con la presencia de sociedades científicas estudiantiles en las carreras, no se logra una plena integración con los centros e institutos de investigación consolidados. No obstante, iniciativas en las que se promueve la participación de jóvenes científicas despierta el interés de las futuras generaciones de investigadores y motiva a sus mentores a la búsqueda de nuevos proyectos y financiamientos.
9. Conclusiones y recomendaciones
El tema de la fragilidad osmótica es un procedimiento muy sencillo que se optimizó para las condiciones de altura. Los resultados ayudarán a la comprensión de la anemia hemolítica y la eritrocitosis. Futuros pasos incluyen el uso de la LDC en los Países Bajos, contribuyendo a la comprensión de la anemia espacial y a las causas de ésta relacionadas con la hiper gravedad.
Por otra parte, es importante el hecho de que científicas mujeres y estudiantes de la Universidad Católica Boliviana representen al país en espacios internacionales, realizando investigaciones de peso a temprana edad y empoderando a la mujer en el campo científico. Esto motiva a que más jóvenes y mujeres se animen a participar de estas oportunidades.
Finalmente, como bolivianos debemos estar conscientes de las limitaciones que existen para hacer ciencia en el país, por lo que se debe procurar la incorporación de nuestros investigadores en las redes internacionales, para poder tener acceso a equipamiento sofisticado. De esta forma Bolivia también tendrá representación en el área científica.